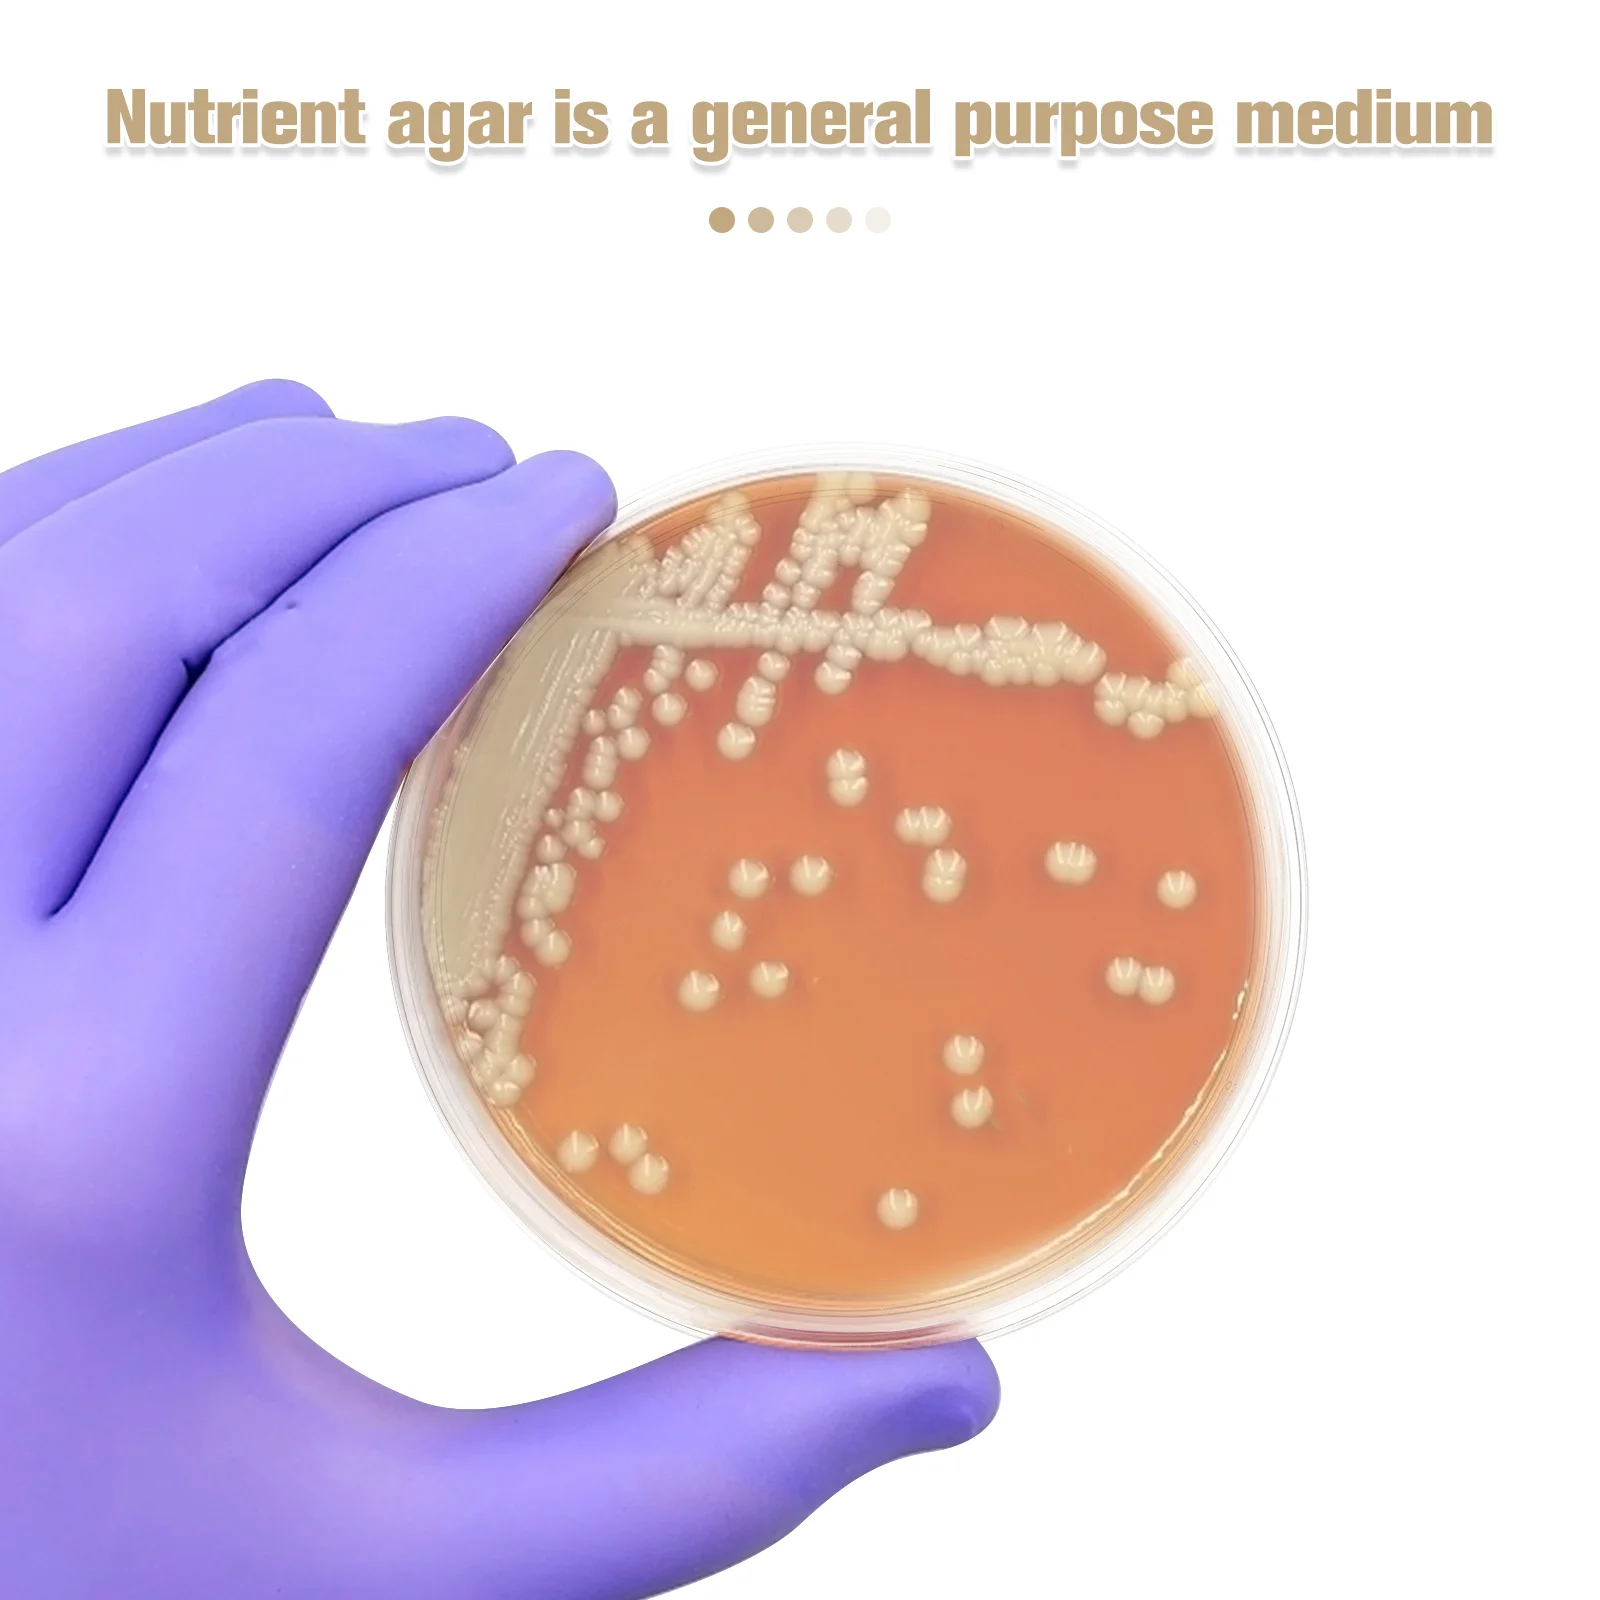

10 шт. набор игрушечных автоклавных стерилизаторов для тестирования пресс-форм
Сохраните в закладки:






История цены
*История изменения цены! Указанная стоимость возможно, уже изменилось. Проверить текущую цену - >
| Месяц | Минимальная цена | Макс. стоимость | Цена |
|---|---|---|---|
| Aug-15-2025 | 2257.91 руб. | 2302.68 руб. | 2279.5 руб. |
| Jul-15-2025 | 1830.99 руб. | 1867.25 руб. | 1848.5 руб. |
| Jun-15-2025 | 2221.87 руб. | 2265.88 руб. | 2243 руб. |
| May-15-2025 | 2203.95 руб. | 2247.37 руб. | 2225 руб. |
| Apr-15-2025 | 1759.85 руб. | 1794.79 руб. | 1776.5 руб. |
| Mar-15-2025 | 2168.93 руб. | 2211.51 руб. | 2189.5 руб. |
| Feb-15-2025 | 2150.36 руб. | 2193.6 руб. | 2171.5 руб. |
| Jan-15-2025 | 2132.1 руб. | 2175.44 руб. | 2153.5 руб. |
Новые товары
Металлические мини-воронки для духов 50 шт |
Стеклянный адаптер для дистилляции Deschem 24/40 |
Колба градуированная HUAOU 100 мл
Стеклянная цилиндрическая бутылка SAIDKOCC 250/500/1000/2000 мл
Лабораторный миксер LanYuXuan
Алюминиевые крышки для флаконов 10-20 мл
Диспергирующий лоток из нержавеющей стали 304
Стеклянная банка для окрашивания волос детские банки Мейсон прозрачный
Характеристики
10 шт. набор игрушечных автоклавных стерилизаторов для тестирования пресс-форм
Описание товара
Трекер стоимости
Отзывы покупателей
Новые отзывы о товарах
Здравствуйте . есть у вас 4 шт. ? ... Читать отзыв полностью...
Yiwu Fente E - Commerce Co Store - недобросовестный продавец с Алиэспресс. 1 сентября сделала заказ (подарок ко дню рождения... Читать отзыв полностью...
Direct 7 day delivery store этот магазин афериста и жуликов не ведитесь на дешёвые товары, обманут и деньги не вернули.... Читать отзыв полностью...
Продавец DKGPD CCC мошенник и нагло лжёт. Отправил другому человеку с указанием моего номера телефона за мои деньги в другой... Читать отзыв полностью...
Эта очень хитрая воровка Не связывайтесь Товар получите не тот что заказывали Или брак-востановлению не подлежит Спор открыть она вам... Читать отзыв полностью...
Очень рекомендую товар этого продавца, я купил гобелен Тайный ужин, имитация жаккардового эффекта, очень-очень красивая, очень-очень хорошая цена, и цена... Читать отзыв полностью...

Здравствуйте, помогите приобрести материнскую плату, не могу нигде найти.... Читать отзыв полностью...